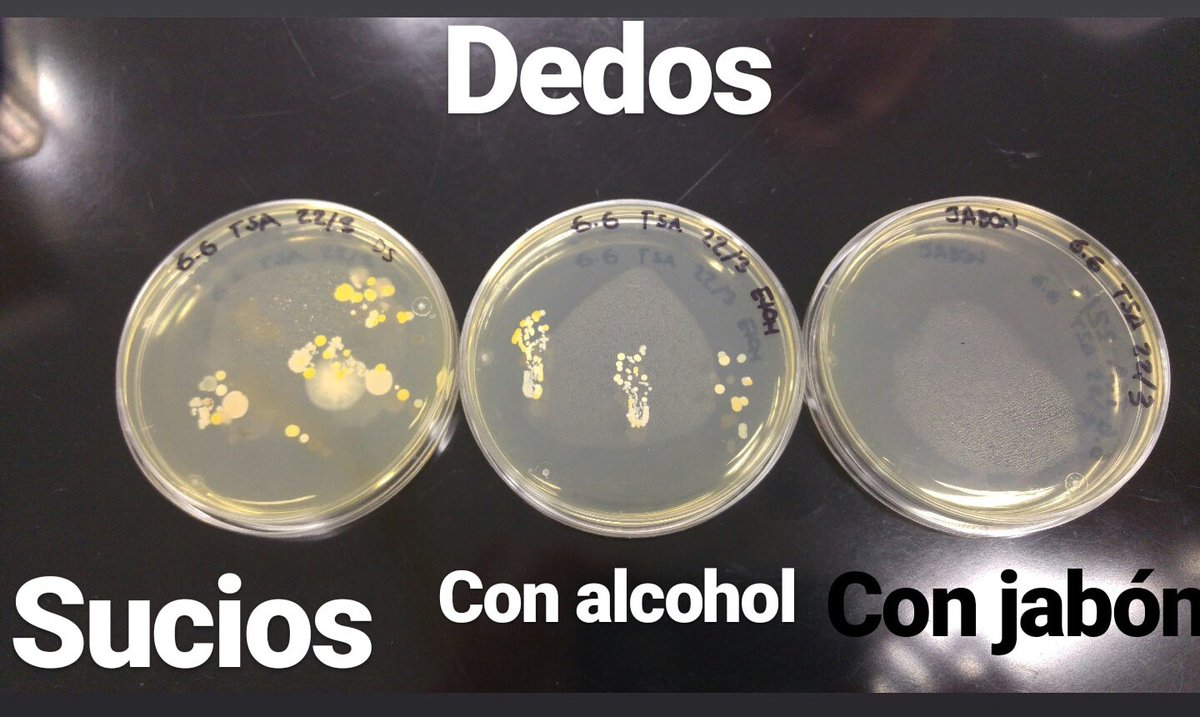
Como el agua y jabón no hay!
Lo que se ve en la foto son colonias de bacterias que están en nuestras manos, creciendo en placas de agar. <a href="/Tomirods/">Tomás Rodríguez</a>

Tomás Rodríguez
@tomirods
ID: 806328808282476544
07-12-2016 02:45:43
157 Tweet
2,2K Followers
31 Following













Como el agua y jabón no hay! Lo que se ve en la foto son colonias de bacterias que están en nuestras manos, creciendo en placas de agar. Tomás Rodríguez

acordando de Tomás Rodríguez que solía sacarse los zapatos en el balcón. estaba en casa porque vivía arriba 😂😂❤️❤️💪🏼💪🏼💪🏼







